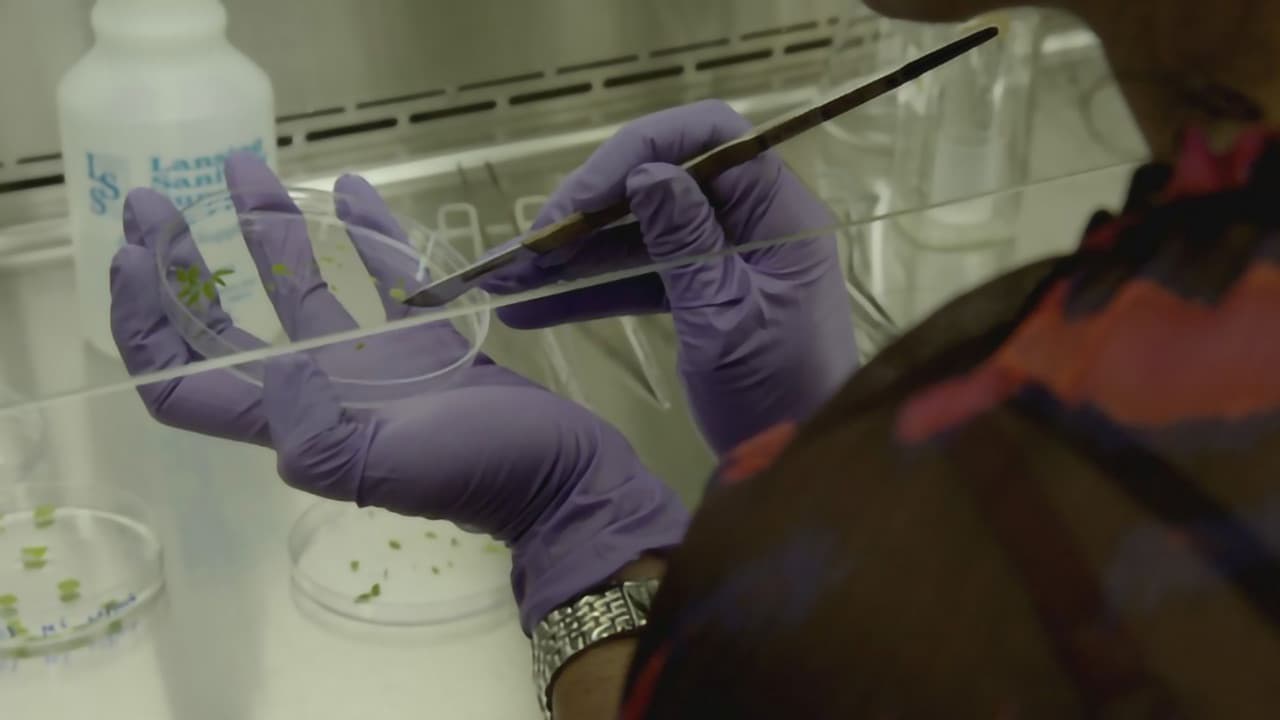
OGM - Mensonges et Vérités

Rex's Fun Facts
Rex is digging up facts...
OGM - Mensonges et Vérités
6.3(3 votes)
2015
0Documentary
healthgmo
Overview
Directed by
Similar Movies
After Haiyan
2014
Daleko od stromu
1957
Navrácený hlas
1954
Exploring the Spectrum
1974
10.0
Secrets toxiques
2023
Super Size Me
2004
6.7
Fat Chance
2017
Naše nohy
1953
Vegan: Everyday Stories
2016
7.7
An Obese World
2020
6.9
Food Matters
2010
6.7
The Future of Food
2004
7.5
The Fittest
2020
5.3
Brains in Danger
2017
7.2
The Connection
2014
6.5
Fat Fiction
2020
6.5
You Might Also Like
Shoah
1985
8.2
Joker
2019
8.1
Back to the Future
1985
8.3
Shutter Island
2010
8.2
American Beauty
1999
8.0
Titanic
1997
7.9
The Exorcist
1973
7.7
The Shawshank Redemption
1994
8.7
Oppenheimer
2023
8.0
Life of Pi
2012
7.4
The Breakfast Club
1985
7.7
The Godfather
1972
8.7
The Dark Knight
2008
8.5
Batman Begins
2005
7.7
Forrest Gump
1994
8.5
Léon: The Professional
1994
8.3
8 Mile
2002
7.1
Dune: Part Two
2024
8.1



































